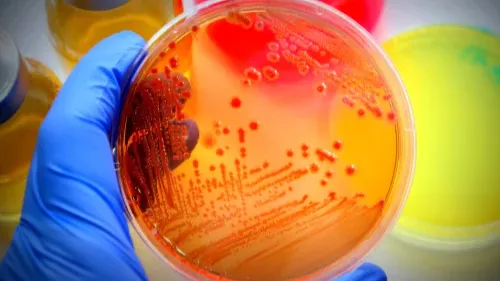
Service Image

At Echelon Hospital, our Microbiology department is dedicated to providing reliable, accurate, and timely diagnostic services. With years of experience, our team understands the vital role microbiology plays in detecting infections, guiding treatments, and maintaining overall health. By combining advanced laboratory techniques with a patient-focused approach, we ensure that every test provides meaningful insights for doctors to make informed decisions.
Microbiology studies microscopic organism’s bacteria, viruses, fungi, and parasites that can affect human health. Some microorganisms are harmless or even beneficial, while others can lead to serious infections if not identified early. Our microbiology services are designed to detect these pathogens efficiently, supporting both preventive care and treatment.
What is Microbiology?
Microbiology is the scientific study of microscopic organisms present in our environment and inside our bodies. While some microorganisms play an essential role in maintaining bodily functions, others can cause infections and diseases. By identifying harmful microorganisms, microbiology tests help doctors determine the best treatment, prevent the spread of infections, and monitor recovery.
In hospital settings, microbiology is essential for early detection of infections, assessing treatment responses, and controlling outbreaks. At Echelon Hospital, our team’s expertise ensures accurate results, giving patients and doctors confidence in every medical decision.
Types of Microbiology Tests
Echelon Hospital provides a wide range of microbiology tests to detect various infections:
- Bacteriology Tests: Identify bacterial infections such as pneumonia, urinary tract infections, and wound infections. These tests guide the selection of effective antibiotics.
- Virology Tests: Detect viral infections like influenza, hepatitis, and COVID-19, enabling timely treatment and prevention of spread.
- Mycology Tests: Diagnose fungal infections affecting skin, nails, or internal organs, especially important for patients with weakened immune systems.
- Parasitology Tests: Identify parasites in blood, stool, or tissue that cause diseases such as malaria, giardiasis, or amoebiasis.
- Antimicrobial Sensitivity Testing: Determines which antibiotics or antiviral medications will work best for the detected infection, helping reduce drug resistance and improve outcomes.
Our comprehensive approach ensures that all possible causes of infections are thoroughly investigated.
Common Microbiology Tests
Some of the key microbiology tests performed at Echelon Hospital includes:
- Bacteriology Tests: Identify bacterial infections such as pneumonia, urinary tract infections, and wound infections. These tests guide the selection of effective antibiotics.
- Virology Tests: Detect viral infections like influenza, hepatitis, and COVID-19, enabling timely treatment and prevention of spread.
- Mycology Tests: Diagnose fungal infections affecting skin, nails, or internal organs, especially important for patients with weakened immune systems.
- Parasitology Tests: Identify parasites in blood, stool, or tissue that cause diseases such as malaria, giardiasis, or amoebiasis.
- Antimicrobial Sensitivity Testing: Determines which antibiotics or antiviral medications will work best for the detected infection, helping reduce drug resistance and improve outcomes.
Each test is performed under strict laboratory standards to ensure accuracy, reliability, and timely reporting.
Our Commitment to Patients
At Echelon Hospital, we see microbiology as more than just laboratory testing it’s about supporting your health and well-being. We are dedicated to:
- Delivering accurate and timely results to assist doctors in providing effective treatment.
- Using advanced technology for reliable detection of infections.
- Ensuring patient comfort with professional guidance and smooth sample collection.
- Providing comprehensive care for all types of infections, from common to complex cases.
- Promoting health awareness so patients understand the importance of early detection and preventive care.
Our microbiology lab acts as a trusted partner in your healthcare journey, offering peace of mind through dependable diagnostic services.
How to Prepare for Microbiology Tests and getting your result prepared
Some microbiology tests require simple preparation to ensure accurate results. For example, fasting may be necessary for certain blood tests and you might need to avoid specific medications if advised by your doctor. It is also important to follow instructions carefully when collecting stool, urine, or swab samples. At Echelon Hospital, our staff provides clear guidance at every step, making the testing process smooth, stress-free, and accurate.
After analysis, results are carefully interpreted by our expert microbiologists. These results help your doctor:
- Identify the type of infection.
- Determine the best treatment plan.
- Monitor recovery and treatment effectiveness.
- Take preventive measures to avoid future infections.
We ensure results are communicated clearly, helping patients understand their health status and next steps.
Supporting Overall Health and Wellness
Microbiology testing does more than detect infections it helps maintain overall wellness. Regular and timely testing can:
- Prevent minor infections from becoming serious.
- Detect early signs of immune or systemic issues.
- Support doctors in designing personalized treatment plans.
- Educate patients about preventive measures to reduce the risk of infections.
By making microbiology an integral part of your health routine, Echelon Hospital helps you stay proactive about your well-being.
Frequently Asked Questions
The duration depends on the test. Rapid tests may take a few hours, while cultures can take 24–72 hours. Your doctor will provide guidance.
Most tests involve simple sample collection, such as blood, urine, or swabs, causing minimal discomfort.
Yes, a doctor’s recommendation ensures the correct test is conducted for accurate diagnosis and treatment.
Yes, antimicrobial sensitivity testing identifies the most effective antibiotics, helping prevent resistance.
The frequency depends on your health condition, symptoms, or ongoing treatment. Your doctor will advise the appropriate schedule.